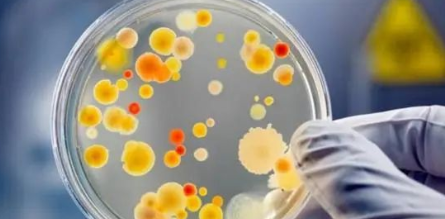
国产69精品久久久久人妻

葡萄酒进口清关是如何检验检疫的呢?华平货代
发布时间:2022-09-02 14:57 文章来源:未知 作者:华平货代 点击:
次
葡萄酒是以新鲜葡萄或葡萄汁为原料,经全部发酵或部分发酵制成的含有一定酒精度的发酵酒。我国大部分葡萄酒都是从国外进口的,进口的葡萄酒会经过多个程序才能到国内进行售卖,接下来就由拥有13年广州葡萄酒进口清关经验的华平货代来带大家了解一下有关进口葡萄酒的检验检疫的过程吧!
一、进口葡萄酒的税号
1、2204.1000:香槟、起泡葡萄酒、葡萄汽酒;
2、2204.2100:装入2L及以下容器的葡萄酒;
3、2204.2200:装入2L以上但不超过10L容器的葡萄酒。
二、葡萄酒进口清关报关申报要素
品名、种类、酒精浓度、级别、年份、产区、酒庄名称、葡萄品种、包装规格、进口方式、品牌等。还须申报进口食品进口商备案号、境外出口商代理商备案号、进口食品境外生产企业注册号;预包装进口葡萄酒的货物属性应申报为“预包装”。海关关员根据新一代查验管理系统下达的指令对进口葡萄酒实施查验和送检,对无需查验和送检的批次直接放行。对抽中需实施检验的批次,要经过层层关卡的考验。
三、进口葡萄酒标签检验
进口葡萄酒标签检验包括:食品名称、配料表、净含量和规格、原产国国名或地区区名(如香港、澳门、台湾)、代理商、进口商或经销者的名称、地址和联系方式、生产日期和保质期、贮存条件、酒精度、警示语。
四、感官及理化检测
1、“一看”:看葡萄酒的外观是否正常,木塞有无霉变、裂纹,酒瓶标签是否清晰无损坏。
2、“二感” :感官检验,看葡萄酒的色泽、澄清程度、起泡程度,闻香气、尝滋味是否正常。
3、“三分析”:对葡萄酒进行前处理后,检测酒精度、总糖、干浸出物、挥发酸、柠檬酸、二氧化碳、总二氧化硫、净含量等理化项目。

五、安全指标检测
葡萄酒的安全指标包括:铁、铜、甲醇、苯甲酸、山梨酸、甜蜜素等。在葡萄酒生产和酿造过程中,有些物质是因工艺需要人为添加的,有些物质是在葡萄种植和发酵过程中自然产生的。这些指标不能超过限量值,否则会对人体健康产生危害。
1、重金属检测——电感耦合等离子体发射光谱质谱仪(ICP-MS)
重金属在人体中累积达到一定程度,会造成慢性中毒。样品经处理后,在离子源的作用下,高温的等离子体使样品中的原子电离出电子而形成一价正离子,然后通过质谱检测离子强度,进而分析出铁、铜等重金属元素的含量。
2、甲醇含量检测——气相色谱仪(GC)
甲醇是葡萄酒发酵时自然产生的有害物质,过量的甲醇摄入会对人体的神经系统和血液系统产生严重影响,造成头疼、恶心、视力模糊甚至失明,严重者可危及生命。利用色谱分离技术和检测技术,可对多组分的复杂混合物进行分析。
3、苯甲酸、山梨酸检测——高效液相色谱仪(HPLC)
苯甲酸、山梨酸作为食品添加剂,主要起防腐作用,但用量过多会对人体产生危害,甚至致癌。应用高效液相色谱原理,可对热不稳定及高沸点的有机化合物进行化学分析。
4、甜蜜素检测——液相色谱质谱联用仪(LC-MS)
甜蜜素是食品饮料制造业中广泛使用的甜味剂,若人体摄入过量,有致癌、致畸、损害肾功能等副作用。结合液相色谱仪对热不稳定及高沸点化合物的有效分离能力与质谱仪强大的组分鉴定能力,可分离分析复杂有机混合物。
六、微生物检测
微生物检验是衡量食品卫生质量的重要指标,葡萄酒属于预包装食品,要经过沙门氏菌、金黄色葡萄球菌等有关微生物检测,并符合国家标准要求。
广州华平国际货代,专业从事广州葡萄酒进口清关服务、保税区报关、物流园报关代理、代理进出口单证、内外贸海运订舱、拖车运输、中港物流、仓储配送等业务,13年老牌好口碑的广州葡萄酒进口清关公司,熟悉各类葡萄酒进口清关手续,服务超百家企业,专业能力强,拥有各种A类资质,24小时全程跟踪服务,用心解决企业进口难题,快速通关!欢迎广大客户来电咨询合作业务:13802957637(微信同号)梁小姐
华平集团旗下的三家全资子公司:华平供应链、华平货代、新天地物流,可为客户提供清关、仓储、运输、配送等一体化服务,以及24小时一对一服务的专业管理团队、客服团队以及操作团队,省去中间复杂的沟通环节、避免供应商相互间的责任推脱
广州华平货代葡萄酒进口清关服务优势:
1、经验丰富,快速通关:我司有十多年广州进出口报关代理经验、在黄埔、南沙等多地有专门办公地点,能帮助客户快速通关,正常情况下,一天内即可清关(包括海关和商检);
2、一对一报关客服:24小时一对一服务的专业管理团队、报关客服团队以及操作团队,省去中间复杂的沟通环节、避免供应商相互间的责任推脱;
3、价格实惠:由于我司经验丰富,能帮助客户避免很多报关的错误,缩短报关时间,帮客户避免很多不必要的延误导致的费用,所以我们能提供给客户更实惠的价格;
4、操作过上千种货物:包括但不限于化工品、食品、水产品、酒水、奶粉、乳制品、危险品、普货、纺织品等,进出口报关代理经验丰富;
5、各港口口岸都可以操作:如保税区报关,广州、深圳、南沙、佛山、白云、番禺、花都、厦门、汕头、上海等地的报关。